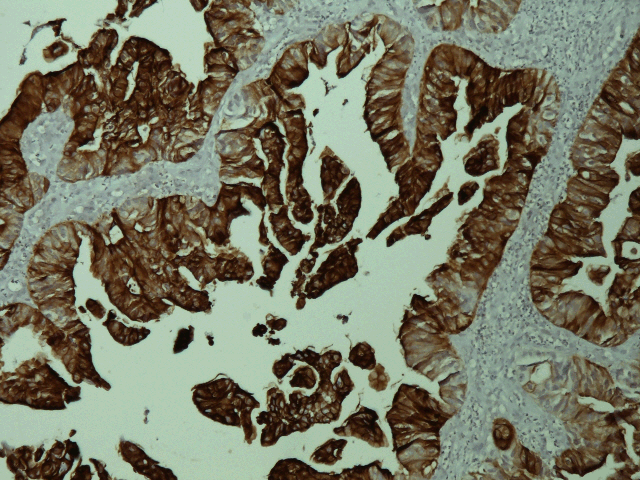

| Table of Contents |  |
|
Case Report
|
| Gingival metastasis from rectal cancer |
| Aymen Lagha1, Nesrine Chraiet1, Sarra Krimi1, Mouna Ayadi1 Hela Rifi1 Henda Raies1 Amel Mezlini1 |
|
1Department of Medical Oncology, Salah Azaiez Institute, Tunis, Tunisia.
|
|
doi:10.5348/ijcri-2012-01-85-CR-7
|
|
Address correspondence to: Aymen Lagha Department of medical oncology Salah Azaiez Institute 1006 Bab Saadoun, Tunis Tunisia Phone: +21624440097 Email: aymen.lagha@hotmail.com |
|
[HTML Abstract]
[PDF Full Text]
|
| How to cite this article: |
| Lagha A, Chraiet N, Krimi S, Ayadi M, Rifi H, Raies H, Mezlini A. Gingival metastasis from rectal cancer. International Journal of Case Reports and Images 2012;3(1):24-26. |
|
Abstract
|
|
Introduction:
Oral cavity is a rare target for metastases. Such lesions are often misdiagnosed and the prognosis is usually poor.
Case Report: We report a case of 46-year-old man who had been diagnosed with rectal tumor, and who presented one year later with a gingival lesion. Initially, primary gingival tumor was evoked, but pathologic examination revealed a gingival metastasis from the rectal cancer diagnosed previously. Conclusion: The importance of this case is to consider the possibility of such metastases and to initiate an appropriate therapy to improve quality of life. | |
|
Key Words:
Gingival metastasis, Rectal cancer
| |
|
Introduction
| ||||||
|
Metastatic involvement in the oral cavity is infrequent, accounting for 1% of all oral malignancies, [1] and involvement of soft tissue is less common compared to the osseous structures. Furthermore, the most common primary sites giving rise to oral metastasis are lung, breast and kidney. [2] Rectal carcinoma is a common neoplasm that metastasizes rarely to the oral region. We report a patient with rectal carcinoma that metastasized to the lower gingiva. The case described here would make physicians suspect such metastases whenever a patient with a past history of colo-rectal cancer presents with a gingival lesion, in order to initiate an appropriate therapy and improve prognosis and quality of life. | ||||||
|
Case Report
| ||||||
|
A 46-year-old man presented to us with complaints of swelling and pain in the lower gingiva. Examination of the oral cavity revealed a deep red and hemorrhagic mass that extend from tooth 27 to tooth 32 (figure 1). Medical history was remarkable for rectal adenocarcinoma for which he had undergone abdominoperineal resection one year earlier (T3N1M0), without any adjuvant treatment. The serum CEA and CA19-9 levels were 44 IU/ml and 19 IU/ml, respectively. A head-neck CT scan showed a 3.6 x 1.5 cm soft tissue mass on the right mandible with involvement of the underlying bone. Pathological examination by biopsy of the gingival tumor revealed moderately differentiated adenocarcinoma. Immunohistochemical (IHC) staining showed negativity for cytokeratin 7 and positivity for cytokeratin 20 (figures 2, 3). The gingival lesion was considered as the metastasis from the rectal cancer. A complete workup revealed liver and lung metastases. The patient underwent chemotherapy with Folfox regimen (oxaliplatin, 5-fluorouracil, leucovorin). It was not well tolerated and the clinical course of the patient was very rapid. His condition deteriorated and he died four months after the diagnosis of gingival metastasis. An autopsy was not performed. | ||||||
| ||||||
| ||||||
| ||||||
|
Discussion
| ||||||
|
Metastatic involvement of the oral region has rarely been reported, and comprises approximately 1% of all oral malignancies. [1] Most of the oral metastasis involves the jawbones, the mandible being the most common site, while involvement of oral soft tissues is rare, and mostly located in the gingiva and tongue. [2] [3] The most common primary sources in decreasing order of frequency are breast, lung, kidney, prostate and colo-rectum. [2] The breast is the most common primary site for tumors metastasizing to the jawbones, whereas the lung is the most common source for metastases to the oral soft tissues. [4] The primary site of metastasis differs between genders. The lung is the most common primary site in males, followed by the kidney, bone and colorectum, whereas in females, the most frequent primary sites are the breast, followed by genital organs and kidney. [4] Hirshberg et al. [2] reported that the colo-rectal origin was found only in 34 cases out of 547 metastatic tumors to soft tissue. The mechanism of metastasis to the oral cavity is mainly hematogenous spread. [5] [6] Gingival metastases may be either a part of a metastatic disease, or the first clinical sign of a primary tumor spread in up to 30% of cases. [7] In this case, the tumor involved the lower gingiva with erosion of the underlying bone, and there was evidence of other distant metastases. Symptoms of oral metastatic tumors consist mainly of pain, swelling, bleeding, neuroparalysis, and deranged dentition. It often presents as a firm polypoid tumor, which can mimic benign lesions such as hemangioma, pyogenic granuloma, periodontal abscess, giant-cell granuloma and peripheral fibroma. [6] [8] The diagnosis, based on pathological study of the lesion, is still difficult because metastatic tumors often show more indifferent histological findings than primary tumor. [9] In the present case, both rectal cancer and gingival tumor proved to be histologically identical, adenocarcinoma subtype, and result of IHC (CK7- and CK20+) was in favor of colo-rectal origin. As the most common histological subtype of primary gingival tumor is a squamous cell cancer, we have considered the gingival lesion an adenocarcinoma in this case as metastasis from rectal cancer. Usually, oral metastases cause a progressive discomfort and even a palliative treatment becomes a necessity to improve the quality of life. There is no effective treatment. Such metastasis in the soft oral tissues should be approached surgically, whatever the spread of the tumor may be. [7] When surgery cannot be performed (tumor widely disseminated) a palliative radiotherapy, chemotherapy or combination of these is recommended. [10] Oral metastases often indicate a poor prognosis with a mean survival time after diagnosis about six months. [3] | ||||||
|
Conclusion
| ||||||
|
Due to their rarity and lack of specific symptoms, soft tissues metastases should be included in the differential diagnosis of gingival lesions in a patient with prior or current malignancy such as rectal cancer, and one should not hesitate to perform a biopsy to establish an accurate diagnosis. | ||||||
|
References
| ||||||
| ||||||
|
[HTML Abstract]
[PDF Full Text]
|
|
Author Contributions:
Aymen Lagha - Substantial contributions to conception and design, acquisition of data, analysis and interpretation of data, Drafting the article and revising it critically for important intellectual content, Final approval of the version to be published Nesrine Chraiet - Substantial contributions to conception and design, Drafting the article, Final approval of the version to be published Sarra Krimi - Substantial contributions to analysis and interpretation of data, Drafting the article, Final approval of the version to be published Mouna Ayadi - Substantial contributions to conception and design, acquisition of data, Revising the article critically for important intellectual content, Final approval of the version to be published Hela Rifi - Substantial contributions to analysis and interpretation of data, Drafting the article, Final approval of the version to be published Henda Raies - Substantial contributions to acquisition of data, Drafting the article, Final approval of the version to be published Amel Mezlini - Substantial contributions to conception and design, acquisition of data, Revising the article critically for important intellectual content, Final approval of the version to be published |
|
Guarantor of submission:
The corresponding author is the guarantor of submission. |
|
Source of support:
None |
|
Conflict of interest:
Authors declare no conflict of interest. |
|
Copyright:
© Aymen Lagha et al. 2012; This article is distributed the terms of Creative Commons Attribution License which permits unrestricted use, distribution and reproduction in any means provided the original authors and original publisher are properly credited. (Please see Copyright Policy for more information.) |
|
|